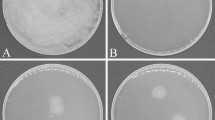

Abstract
Reductive soil disinfestation (RSD) represents an environmentally eco-friendly approach for controlling Fusarium wilt, a prevalent soil-borne disease. This method not only has the potential to suppress disease occurrence but also to enhance the activity of soil microorganisms and nutrients levels. Soil metabolites play a critical role in shaping microbial community composition and regulating pathogen abundance. We designed a potted RSD treatments system to grow melons and applied it to the greenhouse. By evaluating its impacts on melon Fusarium wilt disease occurrence and soil metabolites composition using survey statistics and soil metabolomics sequencing analysis. Our findings revealed that RSD treatments using rice and corn straws significantly markedly diminished the Fusarium wilt disease index. Specifically, pot experiments demonstrated that treatments with rice and corn straw notably increased melon plant height and above-ground biomass. Moreover, through non-targeted metabolomics analysis, we further explored alterations in soil metabolites following treatment with rice and corn straw. The results demonstrated that RSD significantly altered soil metabolites. Differential metabolites were notably enriched in pyrimidine metabolism and ABC transporter pathways. Overall, our results indicate that RSD holds promise in preventing melon Fusarium wilt occurrence while potentially enhancing soil conditions and promoting melon growth by modulating soil metabolites.
Similar content being viewed by others
Introduction
Melon (Cucumis melo L.) holds significant importance in China’s horticultural plant, with advancements in melon production technology rapidly evolving in recent years1. Rich in proteins, carbohydrates, carotene, niacin, calcium, vitamin B, phosphorus, iron, and other, essential nutrients, melons offer various health benefits to humans2. Thriving in warm climates while exhibiting heat resistance, melons are sensitive to low temperature. Across most regions of China, the unique geographical, soil, and climatic conditions provide an ideal environment for melon growth and development, contributing to the improvement of Chinese farmers’ income3,4. In recent years, driven by escalating melon demand and the swift expansion of greenhouse agriculture, greenhouse cultivation has emerged as the predominant method for melon production. However, the exclusive reliance on a singular cultivation approach within greenhouse facilities has led to persistent issues with continuous cropping, severely impeding melon production and yields5,6. This monoculture practice disrupts the equilibrium of soil microorganisms, fostering the accumulation of detrimental pathogens such as Fusarium oxysporum f.sp. melonis, the causative agent of melon Fusarium wilt7,8,9. The pathogen responsible for Fusarium wilt exhibits robust viability in the soil. Fusarium wilt can affect melon production by causing root rot and ultimately leading to plant death10.
Fusarium wilt, a grave soil-borne disease, poses a significant challenge to melon cultivation not only in China but also in regions across Europe, Asia, America, and Africa. Various strategies including fungicides, crop rotation, grafting, and disease-resistant breeding have been employed globally to mitigate this disease. Nevertheless, in China, the predominant approach to combating melon Fusarium wilt revolves around chemical control methods11. Chemical fumigants, extensively used to suppress pathogenic fungi responsible for soil-borne diseases, have unfortunately led to environmental pollution concerns. For instance, methyl bromide, once an effective soil fumigant, was banned in 2004 due to its environmental impact12,13. In light of the principle of prevention first and the pursuit of comprehensive prevention and control measures, an alternative method for managing melon Fusarium wilt has been devised to minimize reliance on chemical agents.
Reductive soil disinfestation (RSD), alternatively known as anaerobic soil disinfestation (ASD) or biological soil disinfestation (BSD), is a widely adopted soil treatment technique in the United States, Netherlands, and Japan14,15,16. Utilized prior to planting, RSD entails creating an anaerobic soil environment through the incorporation of organic materials, soil irrigation, and subsequent coverage with a plastic film4,5,6,7,8,9,10,11,12,13,14,15,16,17. This method serves as a substitute for chemical fumigants in controlling soil-borne diseases. RSD induces an anaerobic soil milieu, fostering the proliferation of anaerobic bacteria engaged in organic matter decomposition18. Research indicates that during RSD treatment, the generation of metal ions, organic acids, hydrogen sulfide, and other compounds inhibits the growth of soil-borne pathogens19,20. Moreover, RSD treatment exerts a beneficial impact on soil microbial diversity and enhances soil physical and chemical properties18,19,20,21. Notably, studies have demonstrated the efficacy of RSD treatment in significantly reducing Fusarium oxysporum populations and managing continuous watermelon cropping17,18,19,20,21,22. The study showed that compared with control treatment soil, RSD significantly decreased Fusarium oxysporum population and the incidence of lisianthus wilt disease to 3.0–14.3%. MiSeq sequencing and culture-dependent investigation showed that the RSD treatments established distinct microbial communities compared to that of the control treatment soil23. RSD significantly improved soil chemical properties, changed the composition and structure of microbial communities, increased microbial diversity, promoted seedling growth, and inhibited the occurrence of cucumber Fusarium wilt24. As an eco-friendly and safe approach, RSD holds promise for preventing soil-borne diseases and ameliorating the soil environment to mitigate challenges associated with continuous cropping.
However, a gap exists in understanding how RSD achieves comprehensive soil enhancement, with existing research predominantly focusing on its impact on soil characteristics25,26. Hence, this study aimed to investigate the effects of RSD treatment on soils subjected to continuous melon cropping, specifically examining the incidence of melon Fusarium wilt and soil metabolic substances. The objective was to identify a safe and effective method for addressing challenges linked to continuous melon cultivation, reducing melon Fusarium wilt occurrence, and assessing the influence of RSD treatment on critical soil metabolites. To achieve these objectives, a greenhouse cultivation experiment was conducted at Shenyang Agricultural University, utilizing five types of straw for RSD soil treatment. This study evaluated the impact of five distinct RSD treatments on melon growth and Fusarium wilt reduction, alongside the identification of changes in soil metabolites and potential metabolic pathways through untargeted metabolomics analysis.
Materials and methods
Study site
The experiment commenced in the greenhouse of the experimental base of Shenyang Agricultural University (41°83′N, 123°57′E), located in Shenyang, Liaoning Province, China. This region experiences an average annual precipitation of 659 mm and a mean temperature of 7.5 °C. The experimental greenhouse soil was identified as brown earth, and melons have been continuously cultivated for 6 years. The melon variety under investigation was “Maohua sweet” (provided by Hebei Maohua Seed Industry Co., Ltd., Hebei, China). Rice, wheat, maize straw, and wheat bran straw used for reductive soil disinfestation treatment was procured from an agroprocessing facility in Lianyungang, Jiangsu Province, China. The purchased straw was dried, mechanically crushed, and sieved through a 0.45 mm sieve to ensure consistent particle size.
Field experimental design
The greenhouse field experiment adopted a random block design comprising six treatments. These treatments were as follows: (1) CK, control, untreated soil; (2) CK-W, soil saturated with irrigation water and covered with transparent polyethylene plastic film (0.08 mm thickness); (3–6) SD, XM, YM, and MF soil supplemented with 1 kg/m² rice, wheat, maize straw, and wheat bran. The soils were saturated with water, covered with plastic film, and all gaps were completely sealed with tape to strictly prohibit air leakage. The greenhouse soil was then incubated at 25–30 °C for 30 days. Following the incubation period, the plastic films were removed, and the soil was allowed to naturally dry. Soil samples from each treatment were collected at the conclusion of the anaerobic treatment and stored at temperatures of 4 °C and − 80 °C for subsequent analysis. Post-sampling, pre-grown seedlings were transplanted into plots corresponding to the different treatments, with each treatment hosting 52 melon seedlings. Subsequently, all melon seedlings were cultivated in the greenhouse for 60 days, maintaining daytime and nighttime temperatures at 28–33 °C and 21–25 °C, respectively. After 60 days, the disease index of the melons was assessed.
Pot experimental design
For the pot experiment, soil was sourced from a greenhouse where melons had been continuously cultivated for six years. Soil samples were meticulously combined, and each polyvinyl chloride box 450 × 330 × 210 mm, length × width × height) was filled with fifteen kilograms of soil. Six treatments were established as follows: (1) CK, control, untreated soil; (2) CK-W, soil irrigated to saturation and covered with transparent polyethylene plastic film (0.08 mm thickness); (3–6) SD, XM, YM, and MF, soil supplemented with 2% (w/w) rice, wheat, maize straw, and wheat bran, respectively, irrigated to saturation, and shielded with plastic film. Each treatment was replicated three times.
The soil-filled boxes were then incubated for 15 days within a culture chamber set at 30 °C. Following the incubation period, the plastic films were removed, and the soil was left to air dry naturally. Subsequently, the soil was transferred into pots (diameter = 115 mm; height = 140 mm) with 1 kg of treated soil, and one pre-grown melon seedling was planted in each pot. Each treatment was replicated three times, with each replicate containing five pots.
All potted melon seedlings were cultivated in a greenhouse for 30 days, maintaining daytime and nighttime temperatures at 28–33 °C and 21–25 °C, respectively. After 30 days, assessments were made for both disease and growth indices of the melon plants.
Analysis of soil metabolites by LC-MS
A metabolic profile analysis was conducted on greenhouse soils treated with corn and rice straw. Each treatment comprised six replicates. Approximately 1 g of soil sample was weighed and transferred to an Eppendorf tube. Subsequently, 1 mL of 80% methanol aqueous solution was added. After vortexing and mixing, the mixture was incubated on ice for 5 min and then centrifuged at 15,000 × g, 4 °C for 15 min. The resulting supernatant was transferred to a new Eppendorf tube and centrifuged again at 15,000 × g, 4 °C for 20 min. The supernatant was then freeze-dried and redissolved with 200 µL methanol. Finally, the solution was injected into a liquid chromatography-tandem mass spectrometry (LC-MS/MS) system. All test samples of equal volume were mixed as quality control (QC) samples. QC samples were tested on the machine before, during, and after LC-MS/MS injection of experimental samples. QC samples were used to evaluate the stability of the entire experimental process and conduct data quality control analysis.
The UHPLC-MS/MS analyses were performed using a Vanquish UHPLC system (Thermo Fisher, Germany) coupled with either an Orbitrap Q Exactive™ HF mass spectrometer or an Orbitrap Q Exactive™ HF-X mass spectrometer (Thermo Fisher) at Novogene Co., Ltd. (Beijing, China). Samples were injected onto a Hypersil Gold column (2.1 mm × 100 mm, 1.9 μm) employing a 12-minute linear gradient at a flow rate of 0.2 mL/min. For the positive polarity mode, eluent A comprised 0.1% formic acid in water, while eluent B was methanol. In the negative polarity mode, eluent A consisted of 5 mM ammonium acetate (pH 9.0), and eluent B was methanol. The solvent gradient was programmed as follows: 2% B for 1.5 min; 2–85% B over 3 min; 85–100% B over 10 min; 100-2% B over 10.1 min; and finally, 2% B for 12 min. The Q Exactive™ HF mass spectrometer was operated in positive/negative polarity mode with a spray voltage of 3.5 kV, capillary temperature of 320 °C, sheath gas flow rate of 35 psi, auxiliary gas flow rate of 10 L/min, S-lens RF level of 60, and auxiliary gas heater temperature of 350 °C.
Data processing and metabolite identification
The raw data files generated by UHPLC-MS/MS underwent processing using Compound Discoverer 3.3 (CD3.3, Thermo Fisher) to conduct peak alignment, peak picking, and metabolite quantitation. Key parameters were configured as follows: peak area normalization was performed utilizing the first QC, with actual mass tolerance set at 5 ppm, signal intensity tolerance at 30%, and minimum intensity thresholds, among others. Subsequently, peak intensities were normalized against the total spectral intensity. The normalized data facilitated the prediction of molecular formulas based on additive ions, molecular ion peaks, and fragment ions. Peaks were then matched against databases including mzCloud (https://www.mzcloud.org/), mzVault, and MassList to yield accurate qualitative and quantitative outcomes. In instances where data deviated from normal distribution, standardization was conducted using the following formula to derive relative peak areas: standardization = raw quantitation value of the sample / (sum of quantitation values of sample metabolites / sum of QC1 sample metabolite quantitation values). Additionally, compounds exhibiting coefficient of variations (CVs) of relative peak areas exceeding 30% in QC samples were excluded. Finally, metabolite identification and relative quantification results were obtained.
Data analysis
The metabolites were annotated utilizing the KEGG (https://www.genome.jp/kegg/pathway.html) and LIPIDMaps (http://www.lipidmaps.org/) databases27–28. Principal Component Analysis (PCA) and Partial Least Squares Discriminant Analysis (PLS-DA) were conducted using metaX, a flexible and comprehensive software for metabolomic data processing29. Principal Component Analysis (PCA) is a statistical method that transforms a set of potentially correlated variables into a set of linearly uncorrelated variables through orthogonal transformation. The transformed variables are referred to as principal components. Partial Least Squares Discriminant Analysis (PLS-DA) is a supervised statistical method for discriminant analysis. This approach employs partial least squares regression to model the relationship between metabolite expression levels and sample categories, thereby enabling the prediction of sample classifications. Univariate analysis (t-test) was applied to determine statistical significance (p-value). Metabolites with VIP > 1 and p-value < 0.05, along with a Fold Change ≥ 2 or ≤ 0.5 (FC), were identified as differential metabolites. Volcano plots were utilized to filter metabolites of interest based on log2 (Fold Change) and -log10 (p-value) using ggplot2 in the R language.
The functions of these metabolites and metabolic pathways were elucidated through the Kyoto Encyclopedia of Genes and Genomes database30. Metabolic pathway enrichment analysis of differential metabolites was conducted; a pathway was considered enriched when meeting the criteria x/n > y/N (x: the number of differential metabolites associated with this pathway; y: the number of all metabolites related to this pathway; n: the number of differentially expressed metabolites annotated by KEGG; N: the number of all metabolites in the background of KEGG annotation), with a corresponding p-value < 0.05 indicating statistical significance. For the analysis of differential metabolites and metabolic pathways, the grouping design was CK vs. SD, and CK vs. YM.
Results
Potted melon wilt disease index and control efficiency
After 30 days of potted melon planting, the disease index and control efficiency were assessed for all treatments (Table 1). The disease indices for the wheat bran, rice, wheat, and maize straw treatments were 27.62, 9.52, 25.71, and 13.33, respectively. The results showed that RSD treatment significantly reduced the melon wilt disease index. In comparison to the control group, rice and maize straw treatments notably reduced the severity of Fusarium wilt by 82.15% and 75.00%, respectively.
Potted melon performance
Thirty days post-melon planting for a total of 30 days, measurements of plant height, stem diameter, and above-ground biomass dry weight were conducted across all treatments (Fig. 1). Melon plant heights in the rice and maize straw treatments were significantly higher than those in the control group and other treatments (Fig. 1a). Moreover, the stem diameter of the wheat bran treatment was notably lower than that of the other treatments (Fig. 1b). Regarding aboveground biomass dry weights, melon plants in the wheat bran and control group treatments exhibited significantly lower values compared to the other treatments (Fig. 1c). These results underscore the superior effects of rice and maize straw treatments on melon performance.
Greenhouse melon wilt disease index and control efficiency
The results presented above suggested that RSD could effectively reduce the incidence rate of melon Fusarium wilt. The RSD was applied to the greenhouse. Sixty days following melon planting in the greenhouse, the disease index and control efficiency were evaluated across all treatments (Table 2). The disease indices for the control, wheat bran, rice, wheat, and maize straw treatments were 55.36, 35.97, 21.43, 34.18, and 23.47, respectively. Compared to the control treatment, the RSD treatment significantly reduced the melon wilt disease index. Specifically, the disease index in the rice and maize straw treatments were significantly lower compared to the control and soil saturated with irrigation water groups. Relative to the control group, the rice and maize straw treatments mitigated the severity of Fusarium wilt by 61.29% and 57.60%, respectively.
Qualitative evaluation of metabolic data and soil metabolites annotated in rice and maize straw treatments
Based on the preceding results, the rice and maize straw treatments emerged as the most effective among the RSD treatments. Consequently, these two soil treatments were chosen for subsequent metabolic analysis. A total of 579 metabolites were identified, encompassing lipids and lipid-like molecules, organic acids and derivatives, organoheterocyclic compounds, benzenoids, phenylpropanoids and polyketides, organic oxygen compounds, nucleosides, nucleotides and analogs, organic nitrogen compounds, as well as alkaloids and their derivatives. PCA revealed distinct metabolic profiles for the rice and maize straw treatments compared to the control group (Fig. 2). Notably, the QC samples exhibited tight clustering, indicating robust method stability and high data quality.
According to KEGG pathway annotation, soil metabolites post-RSD treatment exhibited the highest enrichment in global and overview maps. Amino acid metabolism, lipid metabolism, biosynthesis of other secondary metabolites, chemical structure transformation maps, and metabolism of cofactors and vitamins were among the pathways with increased metabolite enrichment (Fig. 3a). Furthermore, annotation using LIPID MAPS revealed significant enrichment of 22 metabolites in fatty acid and conjugate pathways, with eicosanoids, steroids, and flavonoids showing notable accumulation compared to other metabolites (Fig. 3b).
Annotation of metabolites using the KEGG pathway, HMDB categories, and LIPID MAPS. The horizontal coordinates represent the number of metabolites in all three figures. (aa) The vertical axis represents the annotated KEGG pathways, and the graph shows the number of metabolites. annotated in each secondary classification under the pathway primary classification. (b) The vertical coordinate represents the annotated LIPID MAPS lipid categories, and the graph shows the number of (lipid) metabolites annotated to the main hierarchical category under the seven major lipid cagories in LIPID MAPS.
Quantitative analysis of soil metabolites in rice and maize straw treatments
To elucidate the key soil metabolites responsive to the RSD treatment, various metabolites were analyzed between the two comparison groups of SD vs. CK and YM vs. CK. PCA loading plots revealed significant alterations in different metabolites within each comparison group (Fig. 4a, d). In PLS-DA, the two comparison groups exhibited scores of 43.15% and 43.54% in PC1, respectively (Fig. 4b, e). Following seven-fold cross-validation, the R2 and Q2 values for each comparison group approached 1 (Fig. 4c, f), indicating the appropriateness of the predictive capability and model quality for subsequent experiments. Consequently, based on PCA and PLS-DA analyses, RSD treatments of the rice and maize straw induced significant alterations in soil metabolites.
Statistical analysis for metabolite differences among two comparison groups after RSD treatment. Metabolic data of soil induced by RSD treatment were statistically analyzed among two comparison groups including SD vs. CK and YM vs. CK. (a–d) PCA loading plots. (bb–e) PLS-DA score plots. (c–f) PLS-DA valid plots.
Notably, the rice and maize straw treatments elicited distinct patterns of upregulated and downregulated metabolites across the two comparison groups (Fig. 5a). Relative to control group, rice straw treatment exhibited upregulation of 265 metabolites and downregulation of 108 metabolites, while maize straw treatment showed upregulation of 223 metabolites and downregulation of 181 metabolites (Fig. 5b).
Quantification of different metabolites of soil after RSD treatment. (a) Longitudinal is the clustering of samples, and cross-sectional is the clustering of metabolites, with shorter clustering branches representing higher similarity. The cross-sectional comparison shows the relationship of the clustering of the metabolite content between groups. (b) The graphs indicate the total numbers of significant different metabolites at the corresponding comparison groups, in which black and grey bars stand for the numbers of significantly upregulated (num. of Sig. down) and significantly downregulated different metabolites (num. of Sig. down), respectively.
Differential KEGG pathways activated by rice and maize straw treatments
In order to delve deeper into the metabolic pathways influenced by RSD treatment, KEGG annotation of soil metabolites was conducted. In the SD.vs.CK group, we observed 437 differential metabolites enriched across 125 metabolic pathways. Notably, pyrimidine metabolism emerged as the most enriched pathway, featuring nine distinct metabolites including deoxycytidine, cytidine, thymidine, thymine, uracil, cytosine, dUMP, 2-Deoxyuridine, and uridine, in response to rice straw treatment (Fig. 6a). Additionally, rice straw treatment activated other metabolic pathways such as ABC transporters, biosynthesis of alkaloids derived from ornithine, lysine, and nicotinic acid, galactose metabolism, and 2-Oxocarboxylic acid metabolism.
Top 20 KEGG pathways enriched in different comparison groups after RSD treatment. enrichment statistics of the KEGG pathway in SD vs. CK and YM vs. CK, respectively. The abscissa in the figure is x/y (the rate of the number of differential metabolites in the corresponding metabolic pathway to the total number of metabolites identified in the pathway), and the larger the values indicate, the higher the enrichment of differential metabolites in the pathway. The color of the dot represents the p-value of the hypergeometric test, and the smaller the values stand for, the greater the reliability of the test and the more statistically significant. The size of the dot represents the number of different metabolites in the corresponding pathway. The larger the dot indicates the more differential metabolites in the pathway.
Accordingly, the YM vs. CK group exhibited enrichment of 441 differential metabolites across 107 metabolic pathways, with pyrimidine metabolism being the most prominent pathway associated with maize straw treatment. The identified metabolites included deoxycytidine, cytidine, thymidine, thymine, uracil, cytosine, dUMP, 2-Deoxyuridine, and uridine, alongside tropane, piperidine, pyridine alkaloid biosynthesis, and ABC transporters (Fig. 6b). Maize straw treatment activated other metabolic pathways such as tropane, piperidine and pyridine alkaloid biosynthesis, ABC transporters, biosynthesis, nicotinate and nicotinamide metabolism and 2-Oxocarboxylic acid metabolism. The unique enriched pathways in rice straw treatment included Riboflavin metabolism, Glutathione metabolism, Pentose phosphate pathway, Lysine degradation. The unique enriched pathways in maize straw treatment included Metabolic pathways, Nicotinate and nicotinamide metabolism, Taurine and hypotaurine metabolism, Butanoate metabolism, beta-Alanine metabolism. Remarkably, 15 pathways were found to overlap between the SD vs. CK group and the YM vs. CK group, with pyrimidine metabolism and ABC transporters being predominant among them (Fig. 6a, b). Consequently, based on the pathway enrichment analysis, it is suggested that nucleotide analogs and organic oxygen compounds may play pivotal roles in RSD treatment.
Top 20 differentially abundant metabolites in soil following rice and maize straw treatments
Following the analysis of key soil metabolites in the rice and maize straw treatments, the top 20 differing metabolites in each comparison group were identified based on Fold Change (FC) (Fig. 7a, b). The findings revealed that in the SD.vs.CK group, predominant upregulated metabolites included (+/-)12(13)-DiHOME, D-Ribose, trans-10-Heptadecenoic acid, 12-Epileukotriene B4, 5,6-dimethoxyindan-1-one, among others. Conversely, the main downregulated metabolites encompassed RMH, nicotine, 3-hydroxy-4-methoxy-9 H-xanthen-9-one, methacycline, 6-chloro-1-ethyl-4-oxo-1,4-dihydroquinoline-3-carboxylic acid, catechin, and others (Fig. 6a). In the YM.vs.CK group, notable upregulated metabolites comprised (+/-)12(13)-DiHOME, trans-10-Heptadecenoic acid, D-Ribose, 12-Epileukotriene B4, 5,6-dimethoxyindan-1-one, among others. Conversely, prominent upregulated metabolites included 4-methyl-5-thiazoleethanol, nicotine, caprolactam, methacycline, 3-hydroxy-4-methoxy-9 H-xanthen-9-one, 5-hydroxyindole, and others (Fig. 7b). Interestingly, in both the rice and maize straw treatments, 14 of the top 20 upregulated metabolites were consistent, while 11 of the top 20 downregulated metabolites exhibited similarities.
The top 20 metabolites were upregulated and downregulated in different comparison groups after RSD treatment. The color of the point represents upregulation, blue represents downregulation, and red represents upregulation。The length of the rod represents the size of log2 (Fold Change), FC refers to the difference multiple, which is the ratio of the mean values of all biological repeated quantitative values of each metabolite in the comparison group. The size of the point represents the size of the VIP value, VIP refers to the variable projection importance of the first principal component, which indicates the contribution of metabolites to the subgroup.
Discussion
Control effect of RSD on melon growth and fusarium wilt
By introducing organic materials and anaerobic conditions into the soil, RSD induces alterations in soil characteristics, RSD generates antagonistic compounds during the anaerobic breakdown of organic materials, including ammonia, metal ions, and volatile fatty acid and rapidly eliminates pathogenic fungi31. This method effectively mitigates challenges associated with continuous watermelon cropping and reduces the severity of Fusarium wilt22,23,24,25,26,27,28,29,30,31,32. Study have demonstrated that in soils supplemented with rice and corn straw, the population of Fusarium oxysporum decreased by over 90% within 15 days, thereby significantly alleviating banana Fusarium wilt caused by Fusarium oxysporum f. sp. Cubense33. Our findings indicate that the application of organic materials such as wheat bran and wheat can temporally reduce the severity of Fusarium wilt at appropriate rates of application. The reduction of Fusarium oxysporum populations in the soil through anaerobic fermentation by RSD correlates with decreased severity of melon Fusarium wilt, with rice and corn straw exhibiting the most pronounced effects on melon Fusarium wilt.
Prolonged cultivation of a single crop can result in soil nutrient accumulation and pH fluctuations. As continuous cropping persists, there is a notable decrease in soil pH, significantly impacting plant growth and disease incidence34. Research confirms that continuous melon cropping leads to soil acidification due to declining pH levels, which in turn influences the soil’s physical, chemical, and biological properties35]– [36. RSD treatment significantly elevates soil pH, ameliorates soil acidification, and enhances soil physical and chemical attributes25,26,27,28,29,30,31,32,33,34,35,36,37]– [38. Furthermore, the RSD-treated soils fostered the development of multiple beneficial fungal strains such as Mortierella, Apodospora, and Chrysosporium, which enhance crops’ sustained defensive capacity against pathogenic invasions. Metabolites secreted by beneficial microorganisms promote plant growth17. These modifications likely contribute to increased plant height and aboveground biomass in rice, wheat, and maize straw. Conversely, the biomass of soil saturated with irrigation water did not exhibit significant changes, suggesting that flooding alone does not affect plant growth but aids in pathogen reduction in the soil, consequently lowering Fusarium wilt occurrence. Moreover, the plant height, stem diameter, and aboveground biomass of treatments with MF were the lowest, indicating its limited capacity to promote melon growth.
Effect of RSD on soil metabolites
Soil metabolites, primarily originating from microorganisms and plant roots, constitute vital components influencing plant growth and development39,40,41. While most research on RSD-treated soils has centered on the soil microbiome, studying soil metabolites holds significant importance. In this study, the impact of RSD treatment using rice and corn straw, which exhibited the most substantial effect on melon growth and disease control, was investigated through non-targeted metabolic analysis.
A total of 579 metabolites were detected in the soil, with lipids and lipid-like molecules representing the majority. Post-RSD treatment, notable changes occurred in soil metabolite composition. According to Kyoto Encyclopedia of Genes and Genomes (KEGG) pathway annotation, a higher abundance of metabolites was observed in amino acid and lipid metabolism pathways. Amino acid metabolism has been linked to the regulation of microbial nitrogen utilization42. Elevated levels of total nitrogen (TN), ammonium nitrogen (AN), NH4+-N, and NO3-N following continuous melon cropping adversely impact melon growth and development35. Thus, RSD treatment is speculated to enhance nitrogen utilization by promoting soil amino acid metabolism, potentially mitigating obstacles associated with excessive nitrogen accumulation after continuous cropping43.
Moreover, lipids, serving as cell membrane constituents, play a crucial role in regulating membrane fluidity and are significant components of soil humus, contributing to soil organic carbon (SOC) stability44]– [45. Previous studies underscore the pivotal role of soil metabolites in enhancing soil quality46. This study further analyzed the top 20 metabolites in soil post-RSD treatment. The study showed that the bacterial taxa UC-Rhodothermaceae, UC-BSV40, Clostridium_sensu_stricto_8, UC-Coriobacteriaceae, Microvirga, and Oxobacter, along with the fungal taxa UC-Myriangiales, Sordaria, Trichoderma, and Cutaneotrichosporon most of which were dominant microorganisms in the RSD soil17. Therefore, it is speculated that the metabolites generated during the treatment of rice and corn stover may enhance the growth of beneficial bacteria and fungal, suppress the development of pathogenic bacteria, and stimulate plant growth. Future investigations should prioritize understanding the dynamics of these substances and their contribution to Fusarium wilt prevention and control. Such insights could pave the way for novel targeted treatment strategies aimed at mitigating melon Fusarium wilt and enhancing soil health.
Conclusions
This study illustrates that RSD treatment, as demonstrated through greenhouse and pot experiments, effectively reduces the occurrence of melon Fusarium wilt. Findings from the pot experiment reveal that, except for the wheat bran treatment, melon biomass in the RSD treated pots significantly increased compared to the control group. Moreover, soil metabolites underwent significant alterations following the rice and maize straw treatments, with lipids, lipid-like molecules, organic acids and derivatives, and organoheterocyclic compounds being the most prominently affected metabolite classes. Pathway enrichment analysis suggests potential involvement of nucleotides, analogs, and organic oxygen compounds in RSD treatment effects. Notably, RSD treatment significantly influences soil metabolites, primarily by modulating the abundance of lipids, organic acids, organoheterocyclic compounds, and benzenoids. Differential metabolites are predominantly associated with pyrimidine metabolism and ABC transporter pathways. Overall, our results indicate that RSD holds promise in preventing melon Fusarium wilt occurrence while potentially enhancing soil conditions and promoting melon growth by modulating soil metabolites.
These findings position RSD as a dual-purpose strategy that simultaneously addresses crop protection and soil regeneration in intensive greenhouse systems. For practical implementation, farmers could prioritize rice and maize straw-based RSD treatments fallow periods to maximize both economic returns and organic matter inputs. Future research should investigate changes in microbial communities and metabolites over multiple annual cycles of RSD treatment to ensure the sustainability of this approach.
Data availability
The data that support the findings of this study are available from the corresponding author upon reasonable request. For experts and scholars who need the dataset, please contact gaozenggui@sina.com via email. We will provide the full dataset free of charge for research purposes.
References
Cai, Z. et al. Water and nitrogen management scheme of melon based on yield – quality – efficiency matching perspective under CO2 enrichment. Agric. Water Manage. 285, 108379. https://doi.org/10.1016/j.agwat.2023.108379 (2023).
Song, Z., Liu, S. X., Gao, L., Luan, P., Liu, Z. & F., & Advances of melon breeding technology and method. China Cucurbits Veg. 35, 1–8. https://doi.org/10.16861/j.cnki.zggc.2022.0151 (2022).
Wang, Z., Zhao, J., Mao, S. & Wu, J. Research on the regional advantage layout of china’s melon industry. Chin. J. Agricultural Resour. Reg. Plann. 35 (1), 128–133 (2014).
Yang, N., Sun, Y. & Wu, J. Analysis on the regional advantages of Chinese watermelon and musk-melon industry. China Cucurbits Vegetables. 29 (3), 14–18 (2016).
Ku, Y. et al. Biological control of melon continuous cropping obstacles: weakening the negative effects of the vicious cycle in continuous cropping soil. Microbiol. Spectr. 10 (6). https://doi.org/10.1128/spectrum.01776-22 (2022).
Xie, H. et al. Alleviating Continuous Monocropping Obstacle in Melon: Biological Elimination of Phenolic Acid. Research Square. Version (2020). https://doi.org/10.21203/rs.3.rs-127303/v1
Chen, Y. et al. Evolutions and managements of soil microbial community structure drove by continuous cropping. Front. Microbiol. https://doi.org/10.3389/fmicb.2022.839494 (2022).
Li, M., Wang, J., Zhou, Q. & Yasen, M. Effects of continuous melon cropping on rhizospheric fungal communities. Rhizosphere https://doi.org/10.1016/j.rhisph.2023.100726 (2023).
Mami, I. & Tomomi, S. Potential of Anaerobic Digestates in Suppressing Soil-Borne Plant Disease. Organic Fertilizers, Ch. 16. ^10.5772/intechopen.1001869 (2023).
Wang, X., Zhao, Z., Chen, Q. & Hongbo, S. Identification of control agents against melon wilt disease in laboratory and field in NE China. Pak. J. Bot. 51 (2). https://doi.org/10.30848/PJB2019-2 (2019).
Li, X., Zhao, J., Xu, S. & Wu, X. Research progress on fusarium wilt of muskmelon and its integrated control. China Plant. Prot. 34 (12), 17–21 (2014).
Gamliel, A., Austerweil, M. & Kritzman, G. Non-chemical approach to soilborne pest management – organic amendments. Crop Prot. 19 (8), 847–853. https://doi.org/10.1016/S0261-2194(00)00112-5 (2000).
Liu, L., Huang, X., Zhao, J., Zhang, J. & Cai, Z. Characterizing the key agents in a Disease-Suppressed soil managed by reductive soil disinfestation. Appl. Environ. Microbiol. 85 (7), e02992–e02918. https://doi.org/10.1128/AEM.02992-18 (2019).
Blok, W. J., Lamers, J. G., Termorshuizen, A. J. & Bollen, G. J. Control of soilborne plant pathogens by incorporating fresh organic amendments followed by tarping. Phytopathology® 90 (3), 253–259. https://doi.org/10.1094/PHYTO.2000.90.3.253 (2000).
Domínguez, P. et al. Soil biosolarization for sustainable strawberry production. Agron. Sustain. Dev. 34 (4), 821–829. https://doi.org/10.1007/s13593-014-0211-z (2014).
Mowlick, S., Takehara, T., Kaku, N., Ueki, K. & Ueki, A. Proliferation of diversified clostridial species during biological soil disinfestation incorporated with plant biomass under various conditions. Appl. Microbiol. Biotechnol. 97 (18), 8365–8379. https://doi.org/10.1007/s00253-012-4532-z (2013).
Zhu, W. et al. Influence of reductive soil disinfestation on the chemical and microbial characteristics of a greenhouse soil infested with fusarium oxysporum. Physiol. Mol. Plant Pathol. 118, 101805. https://doi.org/10.1016/j.pmpp.2022.101805 (2022).
Huang, X. et al. Changes in the soil microbial community after reductive soil disinfestation and cucumber seedling cultivation. Appl. Microbiol. Biotechnol. 100 (12), 5581–5593. https://doi.org/10.1007/s00253-016-7362-6 (2016).
Huang, X. et al. Illumina miseq investigations on the changes of microbial community in the fusarium oxysporum f.sp. Cubense infected soil during and after reductive soil disinfestation. Microbiol. Res. 181, 33–42. https://doi.org/10.1016/j.micres.2015.08.004 (2015).
Zhu, R. et al. Efficiency of reductive soil disinfestation affected by soil water content and organic amendment rate. Horticulturae 7 (12), 559. https://doi.org/10.3390/horticulturae7120559 (2021).
Zhu, T., Zhang, J., Yang, W. & Cai, Z. Effects of organic material amendment and water content on NO, N2O, and N2 emissions in a nitrate-rich vegetable soil. Biol. Fertil. Soils. 49 (2), 153–163. https://doi.org/10.1007/s00374-012-0711-4 (2013).
Zhou, K. Prevention and control of continuous cropping obstacle of watermelon by reductive soil disinfestation (RSD). J. Resour. Ecol. 9 (5), 493–499. https://doi.org/10.5814/j.issn.1674-764x.2018.05.006 (2018).
Zhou, X. et al. Control of fusarium wilt of Lisianthus by reassembling the microbial community in infested soil through reductive soil disinfestation. Microbiol. Res. 220, 1–11. https://doi.org/10.1016/j.micres.2018.12.001 (2019).
Ali, A. et al. Deciphering the synergies of reductive soil disinfestation combined with Biochar and antagonistic microbial inoculation in cucumber fusarium wilt suppression through rhizosphere microbiota structure. Microb. Ecol. 85 (3), 980–997. https://doi.org/10.1007/s00248-022-02097-3 (2022).
Qin, F. et al. Reductive soil disinfestation to improve soil properties in long-term tobacco cultivation. Arch. Agron. Soil. Sci. 69 (14), 3284–3299. https://doi.org/10.1080/03650340.2023.2225433 (2023).
Yan, Y. et al. Reductive soil disinfestation enhances microbial network complexity and function. Intensively Cropped Greenh. Soil. 8 (6), 476. https://doi.org/10.3390/horticulturae8060476 (2022).
Kanehisa, M., Furumichi, M., Sato, Y., Matsuura, Y. & Ishiguro-Watanabe, M. KEGG: biological systems database as a model of the real world. Nucleic Acids Res. 53 (D1), D672–D677. https://doi.org/10.1093/nar/gkae909 (2025).
Kanehisa, M. Toward Understanding the origin and evolution of cellular organisms. Protein Sci. 28 (11), 1947–1951. https://doi.org/10.1002/pro.3715 (2019).
Wen, B., Mei, Z., Zeng, C. & Liu, S. MetaX: a flexible and comprehensive software for processing metabolomics data. BMC Bioinform. 18 (1), 183. https://doi.org/10.1186/s12859-017-1579-y (2017).
Kanehisa., M. & Goto, S. K. E. G. G. Kyoto encyclopedia of genes and genomes. Nucleic Acids Res. 28 (1), 27–30. https://doi.org/10.1093/nar/28.1.27 (2000).
Rosskopf, E. N. et al. N.,. Muramoto, D. B. Organic amendments and soil suppressiveness in plant disease management. 277–305. (2015).
Liu, L. et al. Deciphering the Fusarium-wilt control effect and succession driver of microbial communities managed under low-temperature conditions. Appl. Soil. Ecol. 171, 104334. https://doi.org/10.1016/j.apsoil.2021.104334 (2022).
Wen, T. et al. Effects of water regime, crop residues, and application rates on control of fusarium oxysporum f. Sp. cubense. J. Environ. Sci. 31, 30–37. https://doi.org/10.1016/j.jes.2014.11.007 (2015).
Li, Y. et al. Soybean continuous cropping affects yield by changing soil chemical properties and microbial community richness. Front. Microbiol. https://doi.org/10.3389/fmicb.2022.1083736 (2022).
Liu, X. et al. Effects of Broccoli Rotation on Soil Microbial Community Structure and Physicochemical Properties in Continuous Melon Cropping. Agronomy. 13(8), (2066). https://doi.org/10.3390/agronomy13082066 (2023).
Kemmitt, S. J., Wright, D., Goulding, K. W. T. & Jones, D. L. pH regulation of carbon and nitrogen dynamics in two agricultural soils. Soil Biol. Biochem. 38 (5), 898–911. https://doi.org/10.1016/j.soilbio.2005.08.006 (2006).
Meng, T., Ren, G., Wang, G. & Ma, Y. Impacts on soil microbial characteristics and their restorability with different soil disinfestation approaches in intensively cropped greenhouse soils. Appl. Microbiol. Biotechnol. 103 (15), 6369–6383. https://doi.org/10.1007/s00253-019-09964-z (2019).
Zhu, T., Dang, Q., Zhang, J., Müller, C. & Cai, Z. Reductive soil disinfestation (RSD) alters gross N transformation rates and reduces NO and N2O emissions in degraded vegetable soils. Plant. Soil. 382 (1), 269–280. https://doi.org/10.1007/s11104-014-2160-3 (2014).
Li, X. et al. Insights into the mechanisms underlying efficient rhizodegradation of PAHs in biochar-amended soil: from microbial communities to soil metabolomics. Environ. Int. 144, 105995. https://doi.org/10.1016/j.envint.2020.105995 (2020).
Luo, Q., Sun, L. N. & Hu, X. M. Metabonomics study on root exudates of cadmium hyperaccumulator Sedum Alfredii. Chin. J. Anal. Chem. 43 (1), 7–12. https://doi.org/10.1016/S1872-2040(15)60795-2 (2015).
Strehmel, N., Böttcher, C., Schmidt, S. & Scheel, D. Profiling of secondary metabolites in root exudates of Arabidopsis thaliana. Phytochemistry 108, 35–46. https://doi.org/10.1016/j.phytochem.2014.10.003 (2014).
Miller, A. J. & Cramer, M. D. Root nitrogen acquisition and assimilation. Plant. Soil. 274 (1), 1–36. https://doi.org/10.1007/s11104-004-0965-1 (2005).
De Carvalho, C. C. C. R. & Caramujo, M. J. Var. Roles Fat. Acids 23(10), 2583. https://doi.org/10.3390/molecules23102583 (2018).
Doerr, S. H. et al. Extraction of compounds associated with water repellency in sandy soils of different origin. Aust. J. Soil Res. 43 (3), 225–237. https://doi.org/10.1071/SR04091 (2005).
Lorenz, K., Lal, R., Preston, C. M. & Nierop, K. G. J. Strengthening the soil organic carbon pool by increasing contributions from recalcitrant aliphatic bio(macro)molecules. Geoderma 142 (1), 1–10. https://doi.org/10.1016/j.geoderma.2007.07.013 (2007).
Liu, X. et al. Organic amendments alter microbiota assembly to stimulate soil metabolism for improving soil quality in wheat-maize rotation system. J. Environ. Manage. 339, 117927. https://doi.org/10.1016/j.jenvman.2023.117927 (2023).
Funding
This work was supported by Independent Innovation Fund for Agricultural Science and Technology of Ningxia Hui Autono-mous Region (NGSB-2021-10-01), the Special Fund for Agro-scientific Research in the Public Interest (201503110) and Basic scientific research project of Liaoning Provincial Department of Education (JYTQN2023296).
Author information
Authors and Affiliations
Contributions
Author Contributions: X.R.: Methodology, Validation, Investigation, Data curation, Writ-ing-original draft. X.L: Conceptualization, Investigation. Z.Z.: Conceptualization, Investigation. Jialin Shao: Conceptualization, Investigation. Y.H.: Writing-review & editing, Validation, Visuali-zation. Z.G.: Writing-review & editing, Funding acquisition, Project administration.
Corresponding authors
Ethics declarations
Competing interests
The authors declare no competing interests.
Additional information
Publisher’s note
Springer Nature remains neutral with regard to jurisdictional claims in published maps and institutional affiliations.
z,2*Corresponding author.
E-mail address: gaozenggui@sina.com (Z. Gao), huangyufei@syau.edu.cn (Y.H.).
Rights and permissions
Open Access This article is licensed under a Creative Commons Attribution-NonCommercial-NoDerivatives 4.0 International License, which permits any non-commercial use, sharing, distribution and reproduction in any medium or format, as long as you give appropriate credit to the original author(s) and the source, provide a link to the Creative Commons licence, and indicate if you modified the licensed material. You do not have permission under this licence to share adapted material derived from this article or parts of it. The images or other third party material in this article are included in the article’s Creative Commons licence, unless indicated otherwise in a credit line to the material. If material is not included in the article’s Creative Commons licence and your intended use is not permitted by statutory regulation or exceeds the permitted use, you will need to obtain permission directly from the copyright holder. To view a copy of this licence, visit http://creativecommons.org/licenses/by-nc-nd/4.0/.
About this article
Cite this article
Ren, X., Liu, X., Zhang, Z. et al. Effect of reductive soil disinfestation on melon fusarium wilt and soil metabolomics. Sci Rep 15, 23571 (2025). https://doi.org/10.1038/s41598-025-05933-x
Received:
Accepted:
Published:
Version of record:
DOI: https://doi.org/10.1038/s41598-025-05933-x